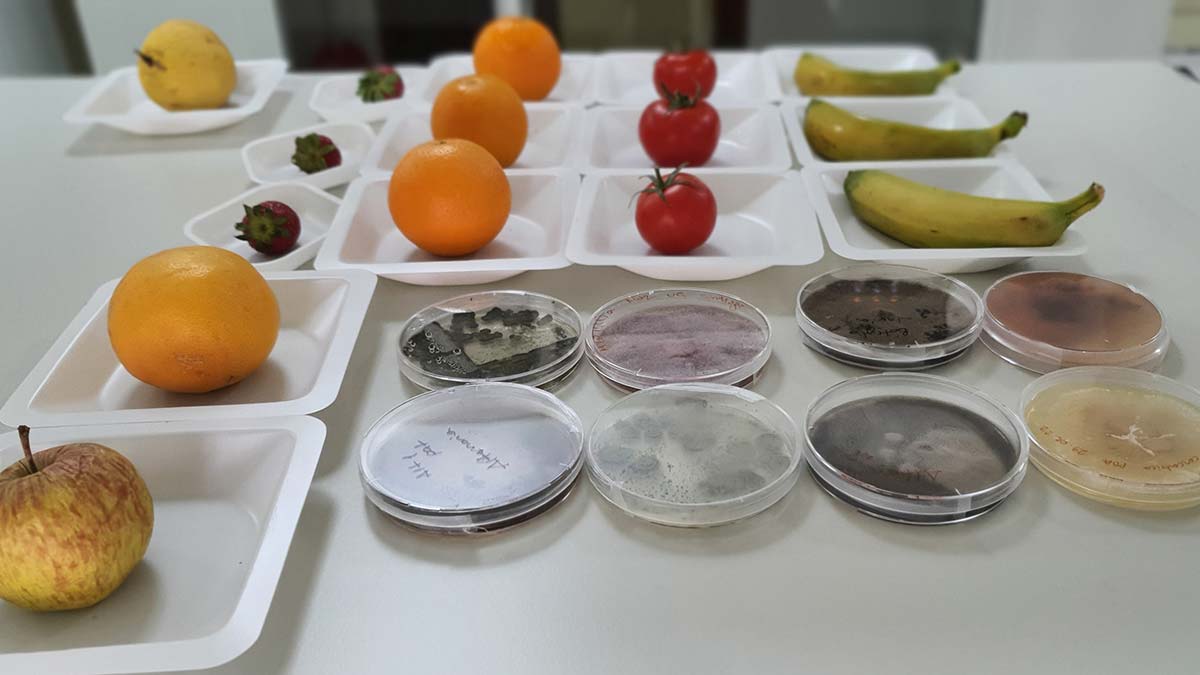
Tarım ve Orman Bakanlığı'nın desteğiyle Sağlık Bilimleri Üniversitesi tarafından yaş meyve ve sebze kaybının önlenmesi amacıyla yeni proje geliştiriliyor.

Tarım ve Orman Bakanlığı’nın desteğiyle Sağlık Bilimleri Üniversitesi tarafından yaş meyve ve sebze kaybının önlenmesi amacıyla yeni proje geliştiriliyor.
Kimyasal madde içermeyen yeni ürünün tarımda geniş ölçekli kullanımı test edilecek. Proje tamamlandığında yılda yaklaşık 26 milyon ton yaş meyve ve sebze kaybının önüne geçileceği belirtiliyor.
Tarım Bakanlığı desteğiyle Sağlık Bilimleri Üniversitesi’nin yürüttüğü projenin 2 yılda tamamlanması planlanıyor. Yaş meyve sebzelerin tarladan raflara, çürüme, bozulma ya da uygun olmayan koşullarda taşınabilmesi için, el ve cilt dezenfektanı olarak kullanılan, kimyasal madde içermeyen yeni bir ürünün tarımda kullanımı test edilecek. Proje tamamlandığında, pestisit adı verilen bakteri, virüs ve haşerelerin zararlı etkilerini ortadan kaldırmak için kullanılan kimyasalların kullanımına gerek kalmayacak. Böylece yaş meyve sebzenin çürümesine engel olunarak, raf ömrü uzatılacak ve yılda yaklaşık 26 milyon ton kaybın önüne geçilecek.

EL DEZENFEKTANINDAKİ MADDE TARIMDA KULLANILACAK
Türk tarımına yeni bir soluk getirecek bu önemli projede, Maltepe Üniversitesi, Gıda Güvenliği Derneği, Adana Biyolojik Mücadele Araştırma Enstitüsü, Alata Bahçe Kültürleri Araştırma Enstitüsü ile Türkiye’nin en büyük zincir marketler grubu ve meyve suyu firmaları işbirliği yapıyor. Projede, pandemi döneminde dezenfektan olarak yaygın olarak kullanılan ve insan sağlığına zarar vermemesiyle de tercih edilen ‘hipokloröz asidin’, tarımda geniş ölçekli kullanımı test edilecek.
Tuzlu suyun elektrolize edilmesiyle elde edilen hipokloröz asit, spreyleme ya da daldırma yöntemiyle tarlada ya da seralarda, yaş meyve sebzeye uygulanacak. Böylece tarım ürünleri hasattan tüketiciye ulaşana dek küf, kir, toz, mantar gibi pekçok nedenle çürümesi engellenmeye çalışılacak. Yöntemin Türkiye koşullarında ne kadar yarar sağladığı ölçülecek, elde edilen veriler, iyi tarım uygulamalarında, hipokloröz asit kullanımının yaygınlaştırılması için kullanılacak. Aynı yöntemin Hollanda, Rusya, Japonya gibi bazı ülkelerde tarımda yaygın olarak kullanılıyor. Ürün, meyve sebzelerde kimyasal atık bırakmaması nedeniyle de dünya tarafından tercih ediliyor.
Projenin yürütücüsü Sağlık Bilimleri Üniversitesi (SBÜ) Rektörü Prof. Dr. Cevdet Erdöl ile SBÜ Hamidiye Sağlık Bilimleri Enstitüsü Biyoteknoloji Anabilim Dalı’ndan Dr. Özge Dinç, projeyi DHA’ya anlattı.
“MEYVE SEBZENİN YÜZDE 50’Sİ DAHA YOLDA ZARAR GÖRÜYOR”
SBÜ Rektörü Prof. Dr. Cevdet Erdöl, BM verilerine göre dünyada yaklaşık 1 milyar kişinin gıdaya ulaşmakta güçlük çektiğini ve 35 bin kişinin de açlıktan öldüğünü vurgulayarak, gıda güvenliğinin hayati önemde olduğuna dikkat çekti. Prof. Dr. Erdöl, “Bunun yansıra ülkemizde ise rakamsal olarak 26 milyon ton kadar gıda bozuluyor, çürüyor, son tüketiciye ulaşana kadar hasar görüyor ve çöpe atılıyor. Zincir marketlerde özellikle meyve sebzelerin yaklaşık yüzde 10’u, tüketiciye hiç ulaşamadan çöpe atılmak zorunda kalıyor.
Kaldı ki tarladan itibaren tüketiciye kadar olan serüven içerisinde, yaş meyve sebzelerin yüzde 50 kadarı da hasar görüyor. Yaş sebze ve meyvelerin raf ömürlerinin uzatılması, çürümelerinin, çöpe atılmalarının engellenmesi için üniversitemizin öncülüğünde bir proje başlatılmış oldu. 2 yıl sürecek olan bu projenin en önemli çıktısı, bu 26 milyon tonun büyük kısmını muhtemelen çöpe atmaktan kurtarmış olacağız. Belki de bu, meyve sebze fiyatlarının da bir noktada artmasını engelleyecek. Bu madde bir pestisit değil. İnsanlara, canlıya zarar veren bir madde olmadığından dolayı da bu yönüyle de önemli. Yaş meyve sebzenin, tarladan sofraya gidecek olan serüven içerisinde, daha sağlıklı taşınabilmelerine imkan verecek” dedi.
“KİMYASAL KALINTI NEDENİYLE ‘İHRAÇ REDDİNİ’ ÖNLEYECEK
SBÜ Hamidiye Sağlık Bilimleri Enstitüsü Biyoteknoloji Anabilim Dalı Öğretim Üyesi Dr. Özge Dinç ise pandemide el ve cilt dezenfektanında kullanılan hipokloröz asitin, Amerikan Gıda ve İlaç Dairesi FDA tarafından da gıda ile teması güvenli olarak sınıflandırıldığını belirtti. Dinç “Ülkemizde de dünyada da yaş meyve ve sebzenin hasadından sonra, çeşitli koruyucu kimyasallar kullanılıyor. Ancak bu kimyasallar hem kalıntı bırakması yönüyle insan sağlığına zarar verebiliyor, hem de ihracat aşamasında gerekli sınır analizlerinin üstünde kalarak, ürünlerin geri dönmesine neden oluyor. Hipokloröz asit, işte bu anlamda hem zararlı kalıntı bırakmaması, hem de mikrobiyal güvenliği üst düzeyde sağlaması yönüyle oldukça avantajlı” dedi.

“TÜRKİYE VERİLERİNİ ELDE ETMEYİ PLANLIYORUZ”
Hipokloröz asidin başta Rusya olmak üzere Japonya ve Hollanda gibi bazı ülkelerde tarım alanında yaygın olarak kullanıldığını belirten Dr. Dinç, Türkiye’de yaygınlaşmamasının nedeninin, şimdiye dek ülkemizdeki tarım ve lojistik koşullarına göre, geniş çaplı bir uygulamada nasıl olacağına dair verilerin olmamasından kaynaklandığını belirtti. Dinç şunları söyledi, “Lojistik zincirindeki fiziksel farklılıklar, hem mesafelerin hem de mevsimin getirdiği sıcaklık farklılıkları, aslında ürünlerin bozulmasına diğer Avrupa ülkelerinden daha fazla etki ediyor.
Bu nedenle bu proje ile biz, ‘Türkiye verilerini’ elde etmeyi amaçlıyoruz. Bu farklı parametrelerin etkisini, Türkiye koşulları için araştırarak kendi ülkemizde hipokloröz asidin tarımda doğru şekilde kullanımını sağlamış olacağız. Lojistik süreçte taşıma koşulları, kasalardan olabilecek bulaş, taşıma araçlarının farklılığından kaynaklı etkiler, depolama alanlarında, hallerdeki bekleme alanlarında oluşabilecek potansiyel patojen bulaşının tespiti gibi bütün faktörleri içeren süreçleri analiz ederek, hipokloröz asidin tarımda yaygın olarak kullanımının doğru konumlandırılmasını hedefliyoruz.”

“BOZULMAYI BİR GÜN BİLE GECİKTİRMEK EKONOMİK KAZANÇ SAĞLAYACAK”
Projeyle meyve sebzede bozulmaların ne kadar önlenebileceği, gıda değerinden kayıp olup olmadığının da ölçüleceğini belirten Dinç “Proje sonuçlandığında ürünün kullanımı Tarım Bakanlığı tarafından da onaylanmış olacak. Bu proje ile hipokloröz asidin ilk defa sahada ‘gerçek ölçekte’ denemelerini yapacağız. Çeşitli veri kaydedicilerle de lojistik ağ boyunca ürünlerin izlenmesini gerçekleştireceğiz.
Proje sonuçlanıp hayata geçirildiğinde, gıdanın bozulmasını bir gün bile geciktirmemiz, bize hem ekonomik bir kazanç sağlayacak, hem de bu proje ile Türkiye’de tarım sektörüne yeni bir soluk getireceğiz” dedi. Dr. Özge Dinç, tuzlu sudan elde edilen hipokloröz asidin laboratuvar ölçeğinde üretilen formunun, kendi imalatları olan jeneratörlerde ayda 15 ton hacme kadar üretebileceğini de belirtti.











